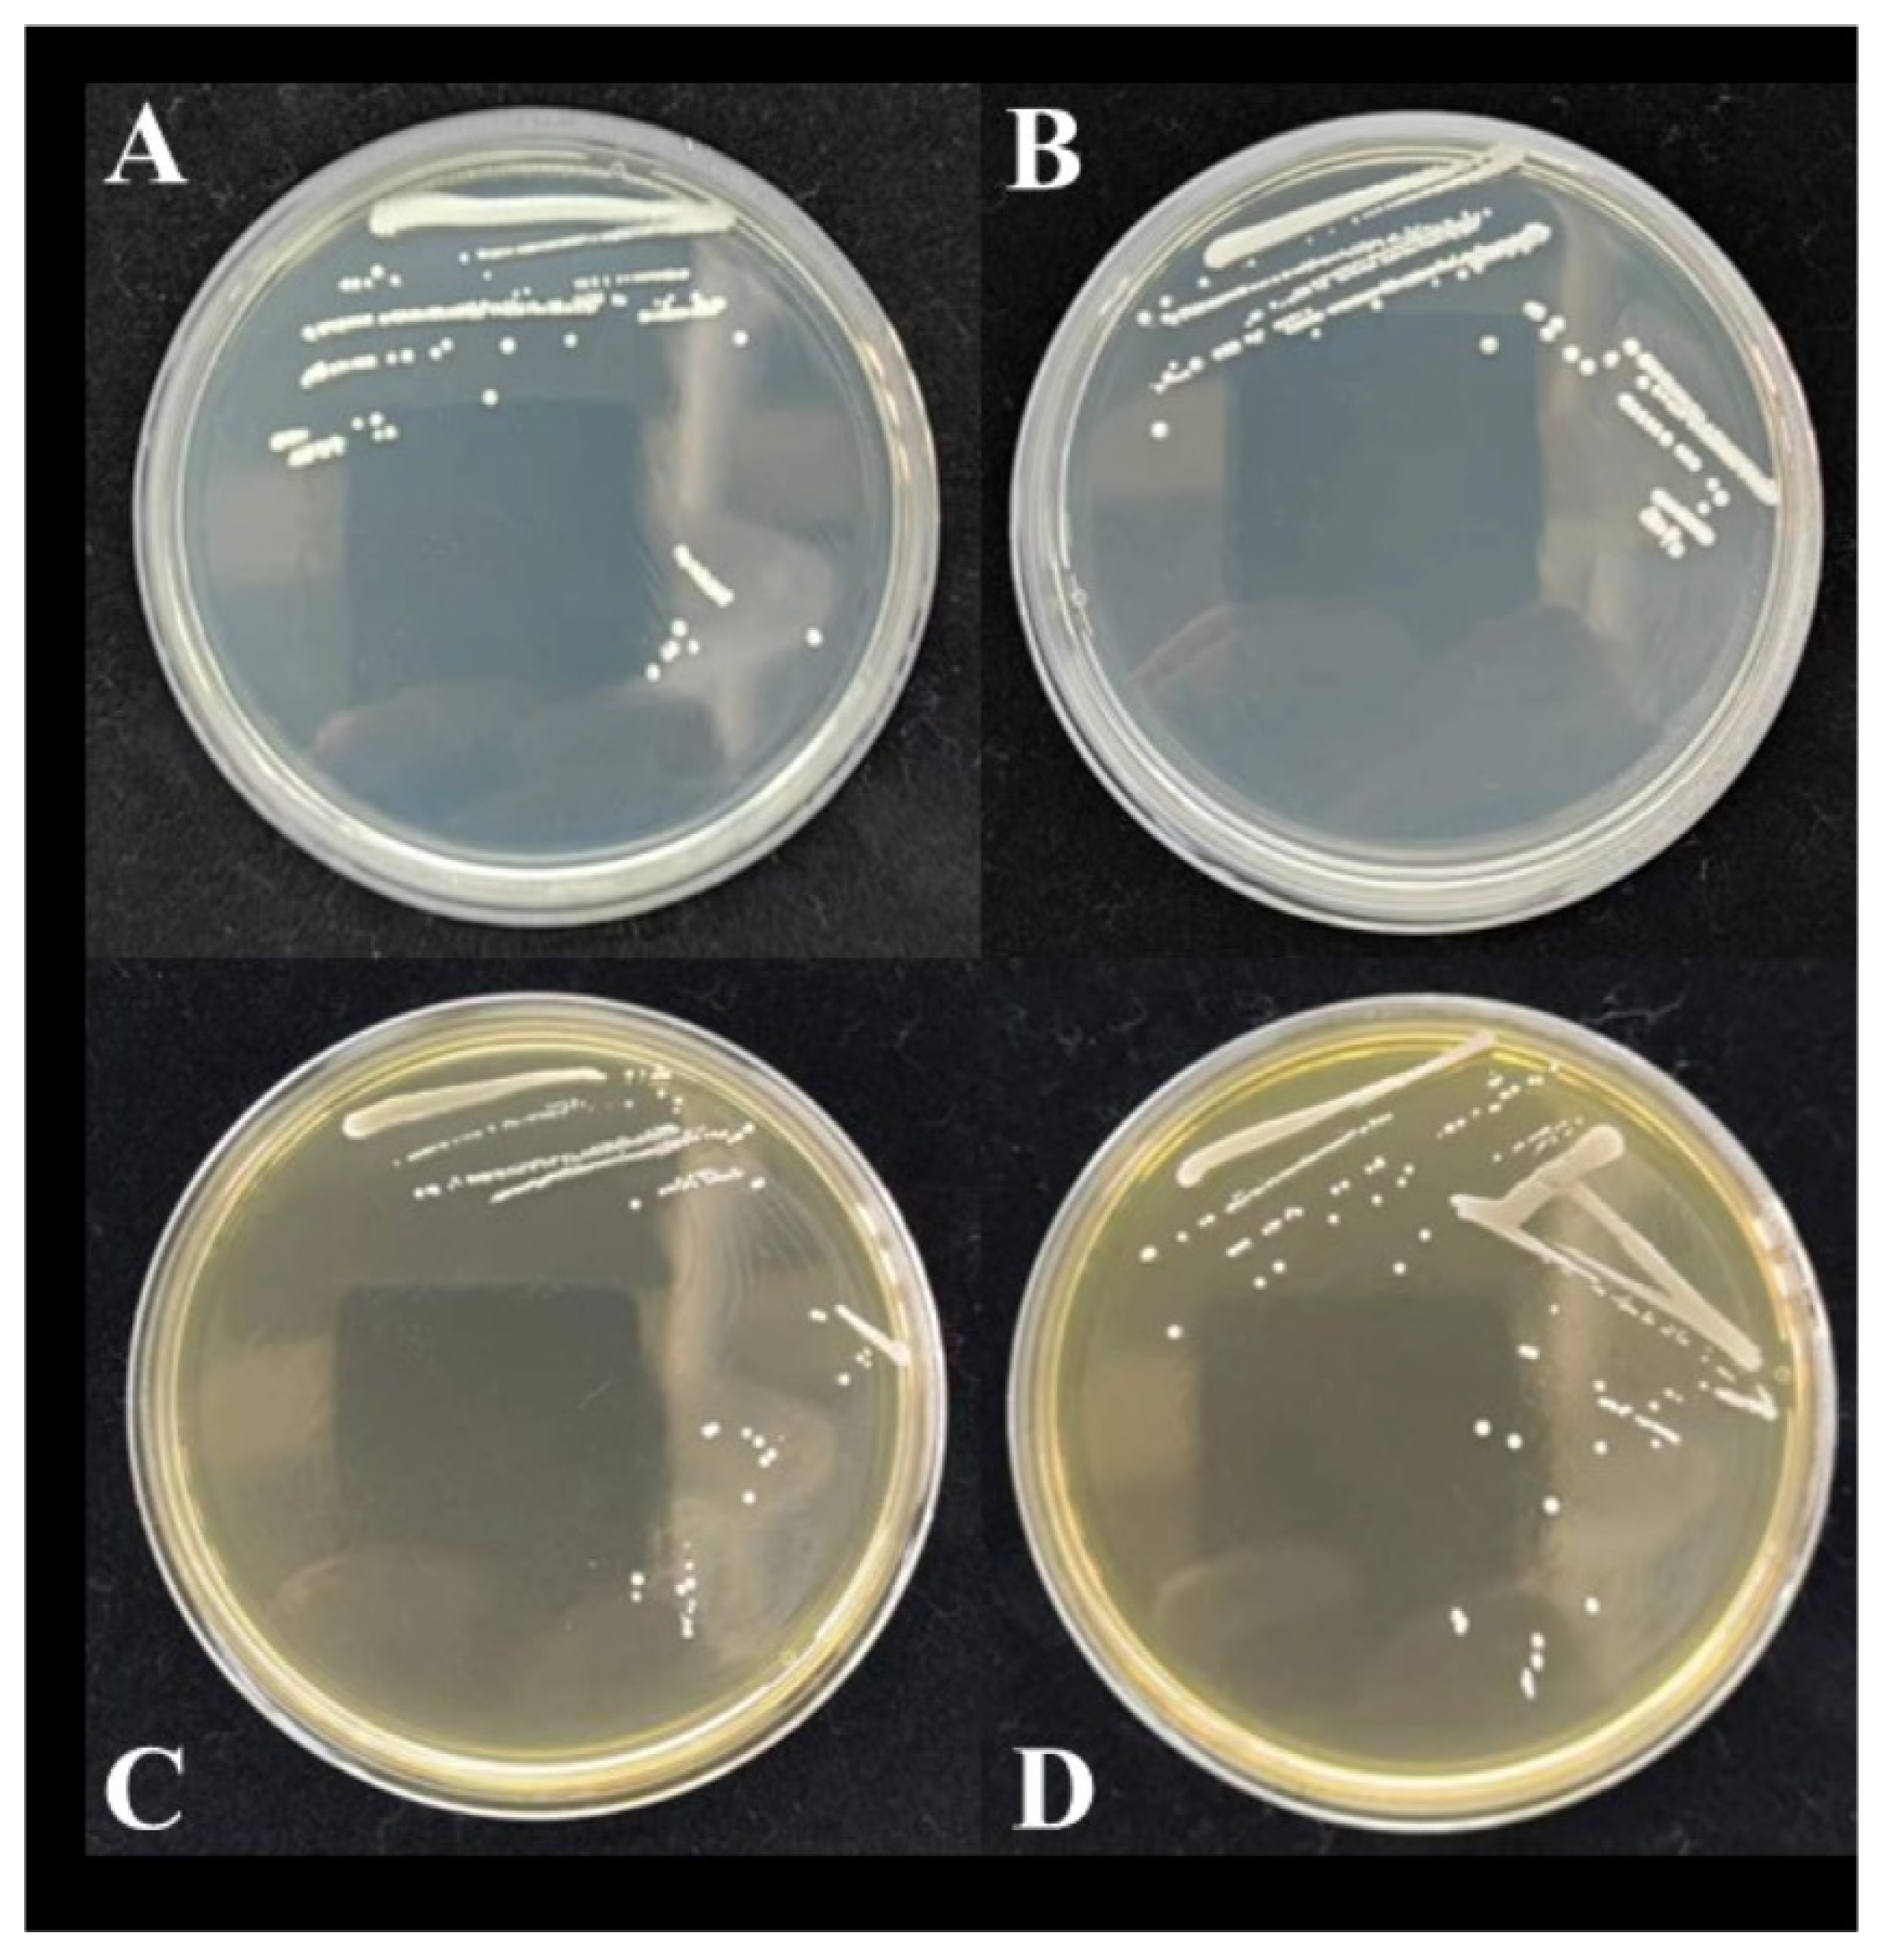
Fermentation 11 00306 g001

Screening, Identification, and Application of Superior Starter Cultures for Fermented Sausage Production from Traditional Meat Products
Abstract
1. Introduction
2. Materials and Methods
2.1. Test Materials
2.1.1. Selection of Fermented Meat Samples and Isolation of Isolates
2.1.2. 16S rRNA Genetic Analysis
2.1.3. Preliminary Safety Screening of Isolates
2.1.4. Stress and Enzyme Production Experiments of Isolates
2.1.5. Growth Characterization and Acid Tolerance Tests of Isolates
2.1.6. Inter-Strain Antagonism Assay
2.2. Preparation of Fermented Sausages
2.3. Sensory Evaluation System of Fermented Sausages
2.4. Determination of Physicochemical Indexes and Texture of Fermented Sausages
2.5. Determination of Volatile Substances in Fermented Sausages
2.6. Statistical Analysis
3. Results and Discussion
3.1. Isolation and Characterization of Microorganisms in Fermented Meat Products
3.2. Results of Preliminary Screening for the Safety of Excellent Fermentation Isolates
3.3. Rescreening Results of Selected Fermentation Isolates
3.3.1. Salt, Sodium Nitrite, and Bile Salt Tolerance of Isolates
3.3.2. Rescreening Results of Fermentation Characteristics
3.3.3. Results of Resistance Assay of Isolates Screened for Fermentation Characteristics
3.4. Taxonomic Identification of Fermentation Isolates
3.4.1. Morphological Characterization of the Isolates
3.4.2. 16S rDNA Gene Sequence Analysis of Selected Isolates
3.5. Growth Characteristics and Acid-Producing Capacity of the Isolates
3.6. Inter-Isolate Antagonism Assay
3.7. Analysis of Physicochemical Indexes of Fermented Sausages
3.7.1. Effect of Different Starters on pH, Moisture Content, Volatile Basic Nitrogen, Sodium Nitrite, and Color of Fermented Sausages
3.7.2. Effect of Different Fermentation Agents on the Textural Properties of Fermented Sausages
3.8. Results of Sensory Evaluation of Fermented Sausages
3.9. Effect of Different Formulas on Volatile Compounds in Fermented Sausages
4. Conclusions
Supplementary Materials
Author Contributions
Funding
Institutional Review Board Statement
Informed Consent Statement
Data Availability Statement
Acknowledgments
Conflicts of Interest
Abbreviations
| LB | Luria-bertani |
| LAB | lactic acid bacteria |
| CoNS | coagulase-negative Staphylococci |
| MRS | Agar de man, rogosa, and sharpe agar |
| TSA | Tryptic soy agar |
| PCR | Polymerase chain reaction |
| BLAST | Basic local alignment search tool |
| NCCLS | National committee for clinical laboratory standards |
| OD | Optical density |
| TVB-N | Total volatile basic nitrogen |
| GC-IMS | Gas chromatography-ion mobility spectrometry |
| PCA | Principal component analysis |
| OAV | Odor activity values |
| VOC | Volatile organic compound |
References
- Zhong, A.; Chen, W.; Duan, Y.; Li, K.; Tang, X.; Tian, X.; Wu, Z.; Li, Z.; Wang, Y.; Wang, C. The potential correlation between microbial communities and flavors in traditional fermented sour meat. LWT-Food Sci. Technol. 2021, 149, 111873. [Google Scholar] [CrossRef]
- Zheng, Y.; Zhao, G.; Zhao, S.; Li, X.; Cui, W.; Xu, L.; Zhu, C.; Tong, L. Don’t judge a sausage by its cover: Effects of inoculating three indigenous lactic acid bacteria on quality, moisture distribution, and protein structure in fermentation. Fermentation 2025, 11, 134. [Google Scholar] [CrossRef]
- Shao, X.; Wang, H.; Song, X.; Huang, M.; Sun, J.; Xu, X. Evolution of free amino acids, biogenic amines and volatile compounds in fermented sausages inoculated with Lactiplantibacillus plantarum and Staphylococcus simulans. Food Sci. Hum. Wellness 2024, 13, 3642–3651. [Google Scholar] [CrossRef]
- Flores, M.; Piornos, A. Fermented meat sausages and the challenge of their plant-based alternatives: A comparative review on aroma-related aspects. Meat Sci. 2021, 182, 108636. [Google Scholar] [CrossRef]
- Ho, H. Ethnic Meat Products|China and Southeast Asia. In Encyclopedia of Meat Sciences, 2nd ed.; Dikeman, M., Devine, C., Eds.; Academic Press: Oxford, UK, 2014; pp. 522–526. [Google Scholar]
- Xiao, Y.; Liu, Y.; Chen, C.; Xie, T.; Li, P. Effect of Lactobacillus plantarum and Staphylococcus xylosus on flavour development and bacterial communities in Chinese dry fermented sausages. Food Res. Int. 2020, 135, 109247. [Google Scholar] [CrossRef]
- Marty, E.; Buchs, J.; Eugster-Meier, E.; Lacroix, C.; Meile, L. Identification of staphylococci and dominant lactic acid bacteria in spontaneously fermented Swiss meat products using PCR–RFLP. Food Microbiol. 2012, 29, 157–166. [Google Scholar] [CrossRef]
- Li, Z.; Su, W.; Mu, Y.; Qi, Q.; Jiang, L. Effects of Pediococcus acidilactici and Rhizopus Oryzae on protein degradation and flavor formation in fermented mutton sausages. LWT-Food Sci. Technol. 2024, 213, 117075. [Google Scholar] [CrossRef]
- Olesen, P.T.; Meyer, A.S.; Stahnke, L.H. Generation of flavour compounds in fermented sausages—The influence of curing ingredients, Staphylococcus starter culture and ripening time. Meat Sci. 2004, 66, 675–687. [Google Scholar] [CrossRef]
- Mu, H.; Weng, P.; Wu, Z. Effect of inoculation with Lacticaseibacillus casei and Staphylococcus carnosus on the quality of squid (Dosidicus gigas) surimi sausage. Fermentation 2023, 9, 794. [Google Scholar] [CrossRef]
- Ferrer-Bustins, N.; Martín, B.; Llauger, M.; Bou, R.; Bover-Cid, S.; Jofré, A. Dynamics of microbial communities in nitrite-free and nutritionally improved dry fermented sausages. Fermentation 2023, 9, 403. [Google Scholar] [CrossRef]
- Zheng, J.; Wang, Z.; Xiang, S.; Tan, Z.; Wu, G.; Zhang, J.; Luo, X.; Wang, L.; Wang, H. Effects of Lactobacillus curvatus SQ-425 and Staphylococcus simulans 65–4 as starter cultures on sensory characteristics, microbial communities and metabolites in fermented sausage. Food Res. Int. 2025, 206, 116030. [Google Scholar] [CrossRef] [PubMed]
- Liu, M.; Luo, H.; Xiao, Q.; Chen, C.; Xu, B.; Li, P. Effect of Latilactobacillus sakei and Staphylococcus xylosus on the textural characteristics of dry fermented sausages. Food Biosci. 2024, 59, 103972. [Google Scholar] [CrossRef]
- Xia, L.; Qian, M.; Cheng, F.; Wang, Y.; Han, J.; Xu, Y.; Zhang, K.; Tian, J.; Jin, Y. The effect of lactic acid bacteria on lipid metabolism and flavor of fermented sausages. Food Biosci. 2023, 56, 103172. [Google Scholar] [CrossRef]
- Milani, G.; Tabanelli, G.; Barbieri, F.; Montanari, C.; Gardini, F.; Belloso Daza, M.V.; Castellone, V.; Bozzetti, M.; Cocconcelli, P.S.; Bassi, D. Technological traits and mitigation activity of autochthonous lactic acid bacteria from mediterranean fermented meat-products. LWT-Food Sci. Technol. 2024, 196, 115861. [Google Scholar] [CrossRef]
- Gallego, M.; Mora, L.; Escudero, E.; Toldrá, F. Bioactive peptides and free amino acids profiles in different types of European dry-fermented sausages. Int. J. Food Microbiol. 2018, 276, 71–78. [Google Scholar] [CrossRef]
- Fan, Y.; Badar, I.; Liu, Q.; Xia, X.; Chen, Q.; Kong, B.; Sun, F. Insights into the flavor contribution, mechanisms of action, and future trends of coagulase-negative staphylococci in fermented meat products: A review. Meat Sci. 2025, 221, 109732. [Google Scholar] [CrossRef]
- Li, H.; Zhu, Q.; Chen, X.; Zhou, J.; Wu, J. Isolation and characterization of coagulase negative staphylococci with high proteolytic activity from dry fermented sausages as a potential starter culture. Food Res. Int. 2022, 162, 111957. [Google Scholar] [CrossRef]
- Madushanka, D.; Vidanarachchi, J.; Kodithuwakku, S.; Nayanajith, G.; Jayatilake, S.; Priyashantha, H. Isolation and characterization of probiotic lactic acid bacteria from fermented traditional rice for potential applications in food and livestock production. Appl. Food Res. 2025, 5, 100865. [Google Scholar] [CrossRef]
- Sengun, Y.; Yalcin, T.; Kilic, G.; Ozturk, B.; Peker, K.; Terzi, Y.; Atlama, K. Identification of lactic acid bacteria found in traditional Shalgam juice using 16S rRNA sequencing and evaluation of their probiotic potential in vitro. Food Biosci. 2024, 60, 104300. [Google Scholar] [CrossRef]
- Yilmaz, N.; Ozogul, Y.; Coşkun, E.; Akyol, İ.; Bhojraj, N.; Reddy, K.; Ozogul, F. Isolation, characterization and antibiotic resistance of lactic acid bacteria from dairy and seafood sources. Food Biosci. 2025, 64, 105895. [Google Scholar] [CrossRef]
- Paik, D.; Lee, Y. Investigation of reduction and tolerance capability of lactic acid bacteria isolated from kimchi against nitrate and nitrite in fermented sausage condition. Meat Sci. 2014, 97, 609–614. [Google Scholar] [CrossRef] [PubMed]
- Cinar, K.; Kaban, G.; Borekci, B.S.; Gulluce, M.; Karadayi, M.; Kaya, M. Identification and characterization of lactic acid bacteria isolated from sucuk, a traditional Turkish dry-fermented sausage. J. Biotech. 2018, 280, S61. [Google Scholar] [CrossRef]
- Chang, K.; Seol, H.; Jeong, G.; Oh, H.; Park, Y.; Perrin, C.; Ham, S. Casein hydrolysis by Bifidobacterium longum KACC91563 and antioxidant activities of peptides derived therefrom. J. Dairy Sci. 2013, 96, 5544–5555. [Google Scholar] [CrossRef]
- Shao, X.; Wang, H.; Song, X.; Xu, N.; Cai, L.; Sun, J.; Xu, X. Decoding the flavor regulation mechanism of fermented sausages inoculated with indigenous strains via metagenomic and GC-MS analysis. LWT 2024, 206, 116604. [Google Scholar] [CrossRef]
- GB 5009.3-2016; National Food Safety Standard—Determination of Moisture Content in Foods. National Standard of the People’s Republic of China: Beijing, China, 2016.
- Leng, T.; Li, F.; Chen, Y.; Tang, L.; Xie, J.; Yu, Q. Fast quantification of total volatile basic nitrogen (TVB-N) content in beef and pork by near-infrared spectroscopy: Comparison of SVR and PLS model. Meat Sci. 2021, 180, 108559. [Google Scholar] [CrossRef]
- GB 5009.33-2016; National Food Safety Standard—Determination of Nitrite and Nitrate in Foods. National Standard of the People’s Republic of China: Beijing, China, 2016.
- Sarvestani, S.; Majdinasab, M.; Golmakani, T.; Shaghaghian, S.; Eskandari, H. Development of a simple and rapid dipstick paper-based test strip for colorimetric determination of nitrate and nitrite in water and foodstuffs. Food Chem. 2024, 461, 140856. [Google Scholar] [CrossRef]
- Kim, J.; Yim, D.; Kang, N. Impacts of Vitis coignetiae Pulliat extract on the physicochemical properties in dry-fermented sausages during storage. LWT-Food Sci. Technol. 2024, 209, 116761. [Google Scholar] [CrossRef]
- Zhang, M.; Zhou, C.; Su, W.; Tan, R.; Ma, L.; Pan, W.; Li, W. Dynamic effects of ultrasonic treatment on flavor and metabolic pathway of pumpkin juice during storage based on GC–MS and GC-IMS. Food Chem. 2025, 469, 142599. [Google Scholar] [CrossRef]
- Yu, M.; Xiang, X.; Tan, H.; Zhang, Q.; Shan, Y.; Yang, H. Potential correlation between volatiles and microbiome of Xiang xi sausages from four different regions. Food Res. Int. 2021, 139, 109943. [Google Scholar] [CrossRef]
- Dutra, P.; Cardoso, P.; Fontes, R.; Silva, G.; Pereira, T.; Ramos, S.; Ramos, M. Combined effects of gamma radiation doses and sodium nitrite content on the lipid oxidation and color of mortadella. Food Chem. 2017, 237, 232–239. [Google Scholar] [CrossRef]
- Lei, S.; Li, X.; Liu, L.; Zheng, M.; Chang, Q.; Zhang, Y.; Zeng, H. Effect of lotus seed resistant starch on tolerance of mice fecal microbiota to bile salt. Int. J. Biol. Macromol. 2020, 151, 384–393. [Google Scholar] [CrossRef] [PubMed]
- Wang, H.; Li, Y.; Xia, X.; Liu, Q.; Sun, F.; Kong, B. Flavour formation from hydrolysis of pork meat protein extract by the protease from Staphylococcus carnosus isolated from Harbin dry sausage. LWT-Food Sci. Technol. 2022, 163, 113525. [Google Scholar] [CrossRef]
- Xu, L.; Li, J.; Zhang, H.; Zhang, M.; Qi, C.; Wang, C. Biological modification and industrial applications of microbial lipases: A general review. Int. J. Biol. Mac. 2025, 302, 140486. [Google Scholar] [CrossRef]
- Abriouel, H.; Casado, M.; Lavilla, L.; Pérez, M.; Bockelmann, W.; Pichner, R.; Kabisch, J.; Cho, G.; Franz, C.; Gálvez, A.; et al. New insights in antibiotic resistance of Lactobacillus species from fermented foods. Food Res Int. 2015, 78, 465–481. [Google Scholar] [CrossRef]
- Kazimoto, T.; Abdulla, S.; Bategereza, L.; Juma, O.; Mhimbira, F.; Weisser, M.; Becker, L. Causative agents and antimicrobial resistance patterns of human skin and soft tissue infections in Bagamoyo, Tanzania. Acta Trop. 2018, 186, 102–106. [Google Scholar] [CrossRef]
- Nunziata, L.; Brasca, M.; Morandi, S.; Silvetti, T. Antibiotic resistance in wild and commercial non-enterococcal Lactic Acid Bacteria and Bifidobacteria strains of dairy origin: An update. Food Microbiol. 2022, 104, 103999. [Google Scholar] [CrossRef]
- Guo, H.; Pan, L.; Li, L.; Lu, J.; Kwok, L.; Menghe, B.; Zhang, H.; Zhang, W. Characterization of antibiotic resistance genes from Lactobacillus isolated from traditional dairy products. J. Food Sci. 2017, 82, 724–730. [Google Scholar] [CrossRef]
- Wang, J.; Li, M.; Wang, J.; Liu, M.; Yang, K.; Zhang, J.; Fan, M.; Wei, X. Antibiotic resistance of coagulase-negative Staphylococci and Lactic Acid Bacteria isolated from naturally fermented Chinese cured beef. J. Food Prot. 2018, 81, 2054–2063. [Google Scholar] [CrossRef]
- Stearns, R.; Freshour, A.; Shen, C. Literature review for applying peroxyacetic acid and/or hydrogen peroxide to control foodborne pathogens on food products. J. Agric Food Res. 2022, 10, 100442. [Google Scholar] [CrossRef]
- Liu, M.; Lin, X.; Yang, J.; Yan, X.; Ji, C.; Liang, H.; Zhang, S.; Dong, L. Effects of salt and rice flour concentration on microbial diversity and the quality of sour meat, a Chinese traditional meat. Food Sci. Hum. Wellness 2024, 13, 2790–2798. [Google Scholar] [CrossRef]
- Xu, B.; Qiu, W.; Liu, Y.; Gong, F.; Liu, Q.; Chen, J.; Tang, Y.; Su, C.; Tang, J.; Zhang, D.; et al. Exploring the regulation of metabolic changes mediated by different combined starter cultures on the characteristic flavor compounds and quality of Sichuan-style fermented sausages. Food Res. Int. 2025, 208, 116114. [Google Scholar] [CrossRef] [PubMed]
- Zhang, Y.; Lu, Y.; Chen, F. Relationship between physicochemical properties and microbial structural distribution of Chinese-style and Salami fermented sausages. Food Biosci. 2023, 53, 102583. [Google Scholar] [CrossRef]
- Zheng, S.; Wang, Y.; Hu, Y.; Yang, L.; Xu, B. Enhancement of fermented sausage quality driven by mixed starter cultures: Elucidating the perspective of flavor profile and microbial communities. Food Res. Int. 2024, 178, 113951. [Google Scholar] [CrossRef]
- Liu, Y.; Mijiti, M.; Xu, Z.; Abulikemu, B. Effect of a combination of probiotics on the flavor profiling and biogenic amines of composite fermented mutton sausages. Food Biosci. 2024, 61, 104835. [Google Scholar] [CrossRef]
- Murtaza, M.; Ur, R.; Anjum, F.; Huma, N.; Hafiz, I. Cheddar cheese ripening and flavor characterization: A review. Crit. Rev. Food Sci. 2014, 54, 1309–1321. [Google Scholar] [CrossRef]
- Hu, Y.; Zhang, L.; Liu, Q.; Wang, Y.; Chen, Q.; Kong, B. The potential correlation between bacterial diversity and the characteristic volatile flavour of traditional dry sausages from Northeast China. Food Microbiol. 2020, 91, 103505. [Google Scholar] [CrossRef]
- Chen, H.; Nie, X.; Peng, T.; Xiang, L.; Liu, D.; Luo, H.; Zhao, Z. Effects of low-temperature and low-salt fermentation on the physicochemical properties and volatile flavor substances of chinese kohlrabi using gas chromatography–ion mobility spectrometry. Fermentation 2023, 9, 146. [Google Scholar] [CrossRef]

| Antibiotic | Concentration (μg /mL) |
|---|---|
| Erythromycin | 150 |
| Penicillin | 100 |
| Tetracycline | 300 |
| Ampicillin | 100 |
| Ciprofloxacin | 50 |
| Gentamicin | 1200 |
| Lincomycin | 20 |
| Ceftriaxone | 300 |
| Chloramphenicol | 300 |
| Cotrimoxazole | 250 |
| The Control Group | Self-Screening Strains Group | The Blank Group | ||||
|---|---|---|---|---|---|---|
| THM-17 | VBL-60 | Formulation 1 | Formulation 2 | Formulation 3 | ||
| Inoculation of ingredients | 2.0% of table salt, 1.8% of glucose, 1.5% of spices, 0.5% of D-sodium erythorbate, 0.5% of monosodium glutamate, 0.01% of sodium nitrite | 2.0% of table salt, 1.8% of glucose, 1.5% of spices, 0.5% of D-sodium erythorbate, 0.5% of monosodium glutamate | ||||
| Starter culture | S. xylosus, P. pentosaceus | S. xylosus, S. carnosus, P. pentosaceus, P. acidilactici | S. saprophyticus and L. sakei were inoculated at a 2:1 (v/v) ratio | S. saprophyticus and L. sakei were inoculated at a 1:1 (v/v) ratio | S. saprophyticus and L. sakei were inoculated at a 1:2 (v/v) ratio | None |
| Total bacterial concentration of 1 × 107 CFU/g | The combined starter culture after Section 2.1 screening, total bacterial concentration of 1 × 107 CFU/g | |||||
| Isolate Source | Isolates | Isolate Code | Isolates Source | Isolates | Isolate Code | Isolates Source | Isolates | Isolate Code |
|---|---|---|---|---|---|---|---|---|
| Xuanwei Ham | Staphylococcus saprophyticus | XW-1 | Pepperoni Salami Slices | Staphylococcus nepalensis | BB-1 | French Saucisson Sec Salami | Latilactobacillus curvatus | OFN-1 |
| Staphylococcus epidermidis | XW-2 | Staphylococcus warneri | BB-2 | Latilactobacillus sakei | OFN-2 | |||
| Staphylococcus pasteuri | XW-3 | Staphylococcus saprophyticus | BB-3 | Staphylococcus carnosus | OFN-3 | |||
| Staphylococcus pasteuri | XW-4 | Staphylococcus pasteuri | BB-4 | Latilactobacillus sakei | OFN-4 | |||
| Staphylococcus epidermidis | XW-5 | Staphylococcus saprophyticus | BB-5 | Latilactobacillus sakei | OFN-5 | |||
| Corynebacterium minutissimum | XW-6 | Staphylococcus saprophyticus | BB-6 | Latilactobacillus sakei | OFN-6 | |||
| Pediococcus acidilactici | XW-7 | Staphylococcus warneri | BB-7 | Latilactobacillus sakei | OFN-7 | |||
| Pediococcus acidilactici | XW-9 | Pediococcus acidilactici | BB-8 | Latilactobacillus sakei | OFN-8 | |||
| Pediococcus acidilactici | XW-10 | Pediococcus acidilactici | BB-9 | Latilactobacillus sakei | OFN-9 | |||
| Pediococcus acidilactici | XW-11 | Staphylococcus epidermidis | BB-10 | Latilactobacillus sakei | OFN-10 | |||
| Pediococcus acidilactici | XW-12 | Staphylococcus warneri | BB-12 | Latilactobacillus sakei | OFN-11 | |||
| — | — | — | — | Latilactobacillus sakei | OFN-12 | |||
| Jinhua Ham | Staphylococcus warneri | JH-1 | Spanish Espetec Salami | Staphylococcus saprophyticus | LH-1 | Spanish-style Salami | Staphylococcus carnosus | YW-1 |
| Staphylococcus epidermidis | JH-2 | Staphylococcus xylosus | LH-2 | Staphylococcus carnosus | YW-2 | |||
| Staphylococcus saprophyticus | JH-3 | Staphylococcus xylosus | LH-3 | Staphylococcus condimenti | YW-5 | |||
| Staphylococcus epidermidis | JH-4 | Staphylococcus saprophyticus | LH-4 | Staphylococcus carnosus | YW-6 | |||
| Staphylococcus pasteuri | JH-5 | Staphylococcus saprophyticus | LH-5 | Staphylococcus xylosus | YW-7 | |||
| Staphylococcus warneri | JH-6 | Staphylococcus xylosus | LH-6 | Staphylococcus xylosus | YW-8 | |||
| Staphylococcus epidermidis | JH-7 | Latilactobacillus sakei | LH-8 | Latilactobacillus sakei | YW-9 | |||
| Staphylococcus warneri | JH-8 | Staphylococcus saprophyticus | LH-9 | Staphylococcus saprophyticus | YW-10 | |||
| Staphylococcus warneri | JH-9 | Staphylococcus carnosus | LH-10 | Staphylococcus xylosus | YW-11 | |||
| Staphylococcus epidermidis | JH-10 | Enterococcus gilvus | LH-11 | Latilactobacillus sakei | YW-12 | |||
| Staphylococcus warneri | JH-11 | Latilactobacillus sakei | LH-12 | — | — | |||
| Staphylococcus saprophyticus | JH-12 | — | — | — | — |
| Isolates | Control Group | 2% | 4% | 6% |
|---|---|---|---|---|
| LH-5 | 1.24 ± 0.03 a | 1.23 ± 0.04 a | 1.21 ± 0.06 b | 1.29 ± 0.06 a |
| LH-9 | 1.27 ± 0.02 a | 1.25 ± 0.04 a | 1.28 ± 0.05 a | 1.24 ± 0.07 a |
| YW-1 | 1.29 ± 0.04 a | 1.28 ± 0.07 a | 1.28 ± 0.08 a | 1.12 ± 0.04 b |
| YW-2 | 1.18 ± 0.03 a | 1.19 ± 0.03 a | 1.14 ± 0.04 a | 1.17 ± 0.06 a |
| YW-5 | 1.31 ± 0.09 a | 1.31 ± 0.06 a | 1.26 ± 0.03 b | 1.29 ± 0.05 a |
| OFN-7 | 1.13 ± 0.02 a | 1.14 ± 0.02 a | 1.17 ± 0.08 a | 1.14 ± 0.03 a |
| OFN-9 | 1.15 ± 0.01 a | 1.14 ± 0.09 a | 1.12 ± 0.02 a | 1.15 ± 0.08 a |
| OFN-11 | 1.14 ± 0.03 a | 1.16 ± 0.03 a | 1.15 ± 0.08 a | 1.16 ± 0.02 a |
| XW-7 | 1.20 ± 0.04 a | 1.18 ± 0.09 a | 1.20 ± 0.04 a | 1.16 ± 0.08 a |
| Isolates | Control Group | 50 mg/L | 100 mg/L | 150 mg/L |
|---|---|---|---|---|
| LH-5 | 1.24 ± 0.03 a | 1.26 ± 0.02 a | 1.20 ± 0.06 a | 1.22 ± 0.07 a |
| LH-9 | 1.27 ± 0.02 a | 1.26 ± 0.07 a | 1.28 ± 0.05 a | 1.25 ± 0.05 a |
| YW-1 | 1.29 ± 0.04 a | 1.30 ± 0.06 a | 1.24 ± 0.08 b | 1.05 ± 0.04 c |
| YW-2 | 1.18 ± 0.03 a | 1.20 ± 0.03 a | 1.18 ± 0.04 a | 1.18 ± 0.06 a |
| YW-5 | 1.31 ± 0.01 a | 1.30 ± 0.07 a | 1.28 ± 0.03 a | 1.30 ± 0.03 a |
| OFN-7 | 1.13 ± 0.02 a | 1.14 ± 0.02 a | 1.12 ± 0.01 a | 1.15 ± 0.02 a |
| OFN-9 | 1.15 ± 0.01 a | 1.17 ± 0.04 a | 1.15 ± 0.02 a | 1.17 ± 0.04 a |
| OFN-11 | 1.14 ± 0.03 a | 1.13 ± 0.03 a | 1.14 ± 0.03 a | 1.15 ± 0.04 a |
| XW-7 | 1.20 ± 0.04 a | 1.18 ± 0.04 a | 1.21 ± 0.04 a | 1.10 ± 0.02 b |
| Isolates | Control Group | 0.1% | 0.2% | 0.4% |
|---|---|---|---|---|
| LH-5 | 1.24 ± 0.03 a | 1.24 ± 0.05 a | 1.10 ± 0.06 b | 0.59 ± 0.07 c |
| LH-9 | 1.27 ± 0.02 a | 1.24 ± 0.06 ab | 1.14 ± 0.05 b | 0.46 ± 0.10 c |
| YW-1 | 1.29 ± 0.04 ab | 1.34 ± 0.01 a | 1.07 ± 0.05 b | 0.64 ± 0.08 c |
| YW-2 | 1.18 ± 0.03 a | 1.10 ± 0.08 a | 1.00 ± 0.09 c | 0.28 ± 0.05 d |
| YW-5 | 1.31 ± 0.01 a | 1.32 ± 0.04 a | 1.07 ± 0.05 b | 0.42 ± 0.07 c |
| OFN-7 | 1.13 ± 0.02 b | 1.26 ± 0.03 a | 1.10 ± 0.02 c | 0.28 ± 0.05 d |
| OFN-9 | 1.15 ± 0.01 a | 1.15 ± 0.04 a | 1.13 ± 0.05 a | 0.54 ± 0.05 b |
| OFN-11 | 1.14 ± 0.03 b | 1.19 ± 0.04 a | 1.18 ± 0.07 a | 0.51 ± 0.08 c |
| XW-7 | 1.20 ± 0.04 a | 1.16 ± 0.02 ab | 1.19 ± 0.06 a | 0.37 ± 0.02 b |
| Isolates | Amino Acid Decarboxylase | Protease Activity | Lipase Activity | Casein Hydrolase | Gas Production Assay |
|---|---|---|---|---|---|
| LH-5 | − | + | + | + | − |
| LH-9 | + | − | + | + | − |
| YW-1 | + | + | + | + | − |
| YW-2 | − | + | + | + | − |
| YW-5 | + | + | + | + | − |
| OFN-7 | − | + | − | − | − |
| OFN-9 | − | + | + | − | − |
| OFN-11 | − | − | + | − | − |
| XW-7 | − | − | − | − | − |
| Antibiotic | Concentration (/disc) | Isolates | |||
|---|---|---|---|---|---|
| LH-5 | YW-2 | OFN-9 | OFN-11 | ||
| Erythromycin | 15 μg | I | I | S | S |
| Penicillin | 1 μg | S | S | S | S |
| Tetracycline | 30 μg | R | I | S | S |
| Ampicillin | 10 μg | S | S | I | I |
| Ciprofloxacin | 5 μg | S | S | R | R |
| Gentamicin | 120 μg | R | I | R | R |
| Lincomycin | 2 μg | R | R | S | S |
| Ceftriaxone | 30 μg | S | S | S | S |
| Chloramphenicol | 30 μg | S | S | S | S |
| Cotrimoxazole | 25 μg | R | R | R | R |
| Isolates | OFN-9 | OFN-11 |
|---|---|---|
| LH-5 | − | − |
| YW-2 | + | − |
| Sample | pH | Moisture Content % | TVB-N mg/100 g | Sodium Nitrite mg/Kg | L* | a* | b* |
|---|---|---|---|---|---|---|---|
| Formulation 1 | 5.70 ± 0.05 a | 19.6 ± 0.1 b | 24.8 ± 0.34 c | 4.00 ± 0.07 b | 41.16 ± 1.23 b | 13.00 ± 0.48 ab | 10.53 ± 0.26 b |
| Formulation 2 | 5.65 ± 0.04 ab | 18.9 ± 0.2 c | 24.1 ± 0.55 c | 3.54 ± 0.05 c | 41.26 ± 1.22 ab | 12.90 ± 0.16 ab | 11.50 ± 0.44 ab |
| Formulation 3 | 5.61 ± 0.08 b | 20.3 ± 0.1 a | 19.2 ± 0.45 d | 3.62 ± 0.12 c | 41.83 ± 1.02 ab | 12.53 ± 0.29 b | 10.33 ± 0.48 b |
| THM-17 | 5.42 ± 0.11 c | 19.6 ± 0.3 b | 31.0 ± 0.21 a | 5.11 ± 0.07 a | 37.43 ± 0.98 c | 12.20 ± 0.18 c | 9.90 ± 0.36 c |
| VBL-60 | 5.34 ± 0.10 d | 19.2 ± 0.2 bc | 27.1 ± 0.65 b | 5.23 ± 0.07 a | 44.63 ± 1.35 a | 13.50 ± 0.15 a | 11.73 ± 0.23 a |
| Sample | Hardness/g | Springiness/mm | Cohesiveness | Chewiness/g·mm |
|---|---|---|---|---|
| Formulation 1 | 4687 ± 335 bc | 1.88 ± 0.03 ab | 0.76 ± 0.11 a | 5228 ± 349 b |
| Formulation 2 | 4804 ± 426 b | 1.85 ± 0.06 ab | 0.66 ± 0.09 b | 6308 ± 485 a |
| Formulation 3 | 4523 ± 230 c | 1.94 ± 0.03 a | 0.55 ± 0.12 c | 6104 ± 479 a |
| THM-17 | 5104 ± 457 b | 1.80 ± 0.11 b | 0.66 ± 0.16 b | 5421 ± 851 b |
| VBL-60 | 5801 ± 689 a | 1.74 ± 0.16 c | 0.56 ± 0.07 c | 4808 ± 575 c |
| Sample | Appearance | Texture | Aroma | Taste | Overall Rating |
|---|---|---|---|---|---|
| Formulation 1 | 15.93 ± 1.78 a | 16.00 ± 1.52 b | 21.13 ± 2.62 a | 21.09 ± 2.00 a | 19.09 ± 2.14 a |
| Formulation 2 | 15.87 ± 1.88 a | 15.73 ± 2.95 c | 20.93 ± 3.01 a | 21.20 ± 1.78 a | 18.60 ± 3.02 b |
| Formulation 3 | 15.62 ± 2.01 a | 16.20 ± 3.20 a | 21.20 ± 1.02 a | 22.06 ± 2.01 a | 19.35 ± 1.89 a |
| THM-17 | 15.23 ± 1.26 ab | 14.80 ± 2.51 e | 17.20 ± 3.58 c | 17.40 ± 2.44 b | 16.95 ± 1.99 c |
| VBL-60 | 14.93 ± 3.32 b | 15.13 ± 3.11 d | 19.26 ± 2.15 b | 15.00 ± 3.29 c | 15.86 ± 2.54 d |
| Relative Content (μg/Kg) | ||||
|---|---|---|---|---|
| Compound | Blank Group | THM-17 | VBL-60 | Formulation 3 |
| Acids | ||||
| Acetic acid | 2396.41 ± 5.11 | 3882.29 ± 91.24 | 4165.68 ± 175.11 | 3264.19 ± 3.32 |
| 2-Methyl propanoic acid | 24.51 ± 0.65 | 17.18 ± 2.62 | 16.44 ± 3.23 | 16.74 ± 1.2 |
| 1-Butanoic acid | 57.69 ± 1.91 | 118.88 ± 6.5 | 107.91 ± 25.73 | 104.27 ± 0.8 |
| 3-Methyl butyric acid | 149.31 ± 1.5 | 199.59 ± 30.26 | 215.37 ± 44.09 | 184.37 ± 12.83 |
| Aldehyde | ||||
| Nonanal | 67.24 ± 7.6 | 93.63 ± 10.08 | 147.23 ± 14.56 | 99.76 ± 3.36 |
| (E)-2-Pentenal | 33.39 ± 4.86 | 24.35 ± 0.96 | 28.6 ± 1.25 | 79.86 ± 1.15 |
| Hexanal | 99.77 ± 4.43 | 44.98 ± 6.5 | 45.83 ± 0.83 | 322.06 ± 0.48 |
| (E)-2-Heptenal | 54.66 ± 1.66 | 21.12 ± 2.5 | 24.63 ± 1.02 | 62.69 ± 0.63 |
| 3-Methyl butanal | 160.34 ± 2.71 | 127.02 ± 8.96 | 156.12 ± 10.46 | 150.12 ± 1.62 |
| (E)-2-Hexen-1-al | 31.25 ± 1.92 | 21.78 ± 3.57 | 24.82 ± 2.95 | 21.57 ± 0.56 |
| Heptaldehyde | 12.25 ± 1.28 | 13.55 ± 6.84 | 6.62 ± 1.23 | 11.42 ± 3.52 |
| 3-(methylsulfanyl)Propanal | 19.95 ± 0.68 | 14.02 ± 1.3 | 14.96 ± 1.96 | 17.19 ± 12.9 |
| 3-Methyl-2-butenal | 5.45 ± 3.89 | 6.11 ± 1.34 | 3.72 ± 0.09 | 3.92 ± 7.01 |
| Butyraldehyde | 94.95 ± 0.59 | 113.79 ± 4.93 | 85.88 ± 5.37 | 155.88 ± 2.06 |
| (E)-2-Pentenal | 6.8 ± 0.75 | 23.07 ± 6.93 | 12.23 ± 2.91 | 12.89 ± 1.71 |
| n-Pentanal | 40.41 ± 4.92 | 79.1 ± 6.6 | 156.03 ± 18.22 | 149.73 ± 7.67 |
| (E)-2-Methylpent-2-enal | 14.44 ± 0.98 | 46.97 ± 16.57 | 63.59 ± 16.48 | 68.21 ± 2.96 |
| Propanal | 123.37 ± 16.86 | 77.71 ± 13.55 | 207.3 ± 19.77 | 251.01 ± 10.43 |
| Octanal | 14.93 ± 0.93 | 16.57 ± 3.42 | 27.53 ± 7.55 | 25.29 ± 4.1 |
| Ketone | ||||
| 2-Heptanone | 34.03 ± 7.41 | 21.24 ± 1.11 | 52.66 ± 7.29 | 16.16 ± 6.24 |
| 2,3-Butanedione | 58.92 ± 0.82 | 43.98 ± 1.23 | 52.93 ± 4.58 | 79.48 ± 0.03 |
| 4-Heptanone | 42.24 ± 1.37 | 8.16 ± 2.14 | 11 ± 0.44 | 11.95 ± 1.46 |
| Acetone | 910.05 ± 296.83 | 862.85 ± 57.69 | 794.58 ± 32.46 | 910.21 ± 19.74 |
| 1-Hydroxy-2-propanone | 52.18 ± 0.10 | 78.09 ± 4.36 | 24.38 ± 4.45 | 23.58 ± 0.16 |
| 2-Butanone | 51.12 ± 0.81 | 87.77 ± 5.88 | 92.21 ± 7.07 | 91.74 ± 1.89 |
| 3-Nonanone | 10.68 ± 0.92 | 15.43 ± 1.33 | 40.77 ± 6.47 | 37.15 ± 6.34 |
| Acetoin | 1638.1 ± 200.65 | 789.6 ± 74.87 | 160.77 ± 59.37 | 120.77 ± 16.58 |
| Alcohol | ||||
| Butanol | 131.79 ± 4.55 | 202.49 ± 1.78 | 235.6 ± 11.3 | 194.32 ± 23.23 |
| Isobutanol | 30.24 ± 2.94 | 58.74 ± 2.58 | 70.76 ± 3.79 | 78.92 ± 5.96 |
| 1-Pentanol | 149.31 ± 3.19 | 99.56 ± 7.8 | 121.37 ± 10.77 | 73.15 ± 1.95 |
| Isoamyl alcohol | 516.06 ± 18.38 | 508.79 ± 13.15 | 590.59 ± 14.97 | 232.74 ± 7.54 |
| Ethanol | 1299.57 ± 0.95 | 1013.2 ± 87.22 | 946.65 ± 31.41 | 1278.65 ± 0.53 |
| 3-Methyl-3-buten-1-ol | 42.20 ± 2.54 | 10.20 ± 0.69 | 10.21 ± 1.24 | 12.08 ± 0.52 |
| 1-Penten-3-ol | 61.94 ± 3.07 | 21.76 ± 8.02 | 24.97 ± 3.22 | 28.84 ± 1.08 |
| (Z)-2-Penten-1-ol | 29.53 ± 7.37 | 14.44 ± 3.46 | 13.56 ± 0.22 | 13.78 ± 10.03 |
| 2-Pentanol | 14.52 ± 115.13 | 40.64 ± 6.06 | 37.45 ± 3.93 | 45.25 ± 104.35 |
| Propanol | 18.59 ± 0.5 | 73.69 ± 3.49 | 52.43 ± 2.6 | 59.84 ± 0.37 |
| 2-Propanol | 12.51 ± 6.27 | 32.09 ± 3.67 | 31.08 ± 1.55 | 31.07 ± 10.36 |
| 2-Heptanol | 22.06 ± 2.85 | 25.92 ± 2.34 | 81.5 ± 11.84 | 88.12 ± 11.36 |
| Ester | ||||
| Ethyl butyrate | 62.95 ± 3.05 | 81.73 ± 1.4 | 80.95 ± 2.71 | 98.63 ± 0.91 |
| Butanoic acid 3-methyl, ethyl | 21.46 ± 0.97 | 14.29 ± 1.77 | 9.29 ± 0.08 | 11.20 ± 0.38 |
| 1-Butanol, 3-methyl-, acetate | 14.47 ± 11.49 | 6.71 ± 1.86 | 2.20 ± 0.23 | 2.01 ± 16.8 |
| Ethyl acetate | 175.06 ± 1.89 | 209.02 ± 22.62 | 122.75 ± 1.9 | 244.75 ± 2.44 |
| Butanoic acid, 3-methylbutyl | 15.82 ± 2.44 | 10.07 ± 1.19 | 7.31 ± 1.19 | 5.48 ± 2.1 |
| Hexyl formate | 13.24 ± 1.07 | 24.69 ± 4.33 | 16.68 ± 2.38 | 14.53 ± 0.75 |
| 1,2-Propanediol diacetate | 243.41 ± 0.49 | 466.68 ± 59.25 | 340.49 ± 47.63 | 447.25 ± 0.27 |
| 2-Methylbutanoic acid, methyl | 1.85 ± 9.93 | 4.93 ± 1.12 | 2.96 ± 0.61 | 2.84 ± 1.04 |
| Methyl benzoate | 426.63 ± 3.45 | 579.27 ± 165.08 | 555.84 ± 301.16 | 599.45 ± 6.29 |
| Hexyl propanoate | 15.83 ± 3.43 | 15.13 ± 2.87 | 30.42 ± 2.97 | 31.56 ± 1.01 |
| Other | ||||
| α-Pinene | 87.83 ± 4.31 | 80.07 ± 5.22 | 71.9 ± 11.16 | 157.71 ± 0.86 |
| δ-3-carbene | 42.22 ± 9.57 | 35.18 ± 3.18 | 36.45 ± 4.22 | 63.72 ± 6.1 |
| 2-Methylpyrazine | 13.36 ± 14.63 | 13.73 ± 1.67 | 12.72 ± 0.92 | 18.12 ± 37.39 |
| (Z)-2-Pentenal | 7.53 ± 0.53 | 10.01 ± 0.36 | 8.55 ± 0.4 | 4.55 ± 1.77 |
| 2-Acetylfuran | 16.48 ± 4.48 | 32.5 ± 5.16 | 30.8 ± 3.46 | 35.89 ± 12.89 |
| (+)-Limonene | 3.09 ± 1.16 | 3.7 ± 0.26 | 2.08 ± 0.2 | 2.89 ± 2.13 |
| α-Terpinene | 27.87 ± 1.06 | 43.34 ± 7.82 | 21 ± 2.2 | 21.07 ± 1.88 |
| β-Thujene | 29.33 ± 0.86 | 48.98 ± 6.4 | 34.15 ± 4.44 | 34.15 ± 1.36 |
| Tetrahydrofuran | 112.21 ± 2.1 | 326.28 ± 31.49 | 275.59 ± 32.4 | 175.19 ± 2.79 |
| β-Cubebene | 33.48 ± 0.36 | 77.31 ± 22.03 | 64.20 ± 10.68 | 64.28 ± 0.37 |
| 2,3-Diethyl-5-methylpyrazine | 16.4 ± 0.83 | 51.61 ± 3.14 | 45.53 ± 0.89 | 52.07 ± 2.71 |
Disclaimer/Publisher’s Note: The statements, opinions and data contained in all publications are solely those of the individual author(s) and contributor(s) and not of MDPI and/or the editor(s). MDPI and/or the editor(s) disclaim responsibility for any injury to people or property resulting from any ideas, methods, instructions or products referred to in the content. |
© 2025 by the authors. Licensee MDPI, Basel, Switzerland. This article is an open access article distributed under the terms and conditions of the Creative Commons Attribution (CC BY) license (https://creativecommons.org/licenses/by/4.0/).
Share and Cite
Dong, Z.; Wang, L.; Ge, Y.; An, Y.; Sun, X.; Xue, K.; Xie, H.; Wang, R.; Li, J.; Chen, L. Screening, Identification, and Application of Superior Starter Cultures for Fermented Sausage Production from Traditional Meat Products. Fermentation 2025, 11, 306. https://doi.org/10.3390/fermentation11060306
Dong Z, Wang L, Ge Y, An Y, Sun X, Xue K, Xie H, Wang R, Li J, Chen L. Screening, Identification, and Application of Superior Starter Cultures for Fermented Sausage Production from Traditional Meat Products. Fermentation. 2025; 11(6):306. https://doi.org/10.3390/fermentation11060306
Chicago/Turabian StyleDong, Zijie, Longfei Wang, Yanzheng Ge, Yongqiang An, Xiaoxue Sun, Ke Xue, Haoyang Xie, Ran Wang, Junguang Li, and Lishui Chen. 2025. "Screening, Identification, and Application of Superior Starter Cultures for Fermented Sausage Production from Traditional Meat Products" Fermentation 11, no. 6: 306. https://doi.org/10.3390/fermentation11060306
APA StyleDong, Z., Wang, L., Ge, Y., An, Y., Sun, X., Xue, K., Xie, H., Wang, R., Li, J., & Chen, L. (2025). Screening, Identification, and Application of Superior Starter Cultures for Fermented Sausage Production from Traditional Meat Products. Fermentation, 11(6), 306. https://doi.org/10.3390/fermentation11060306

